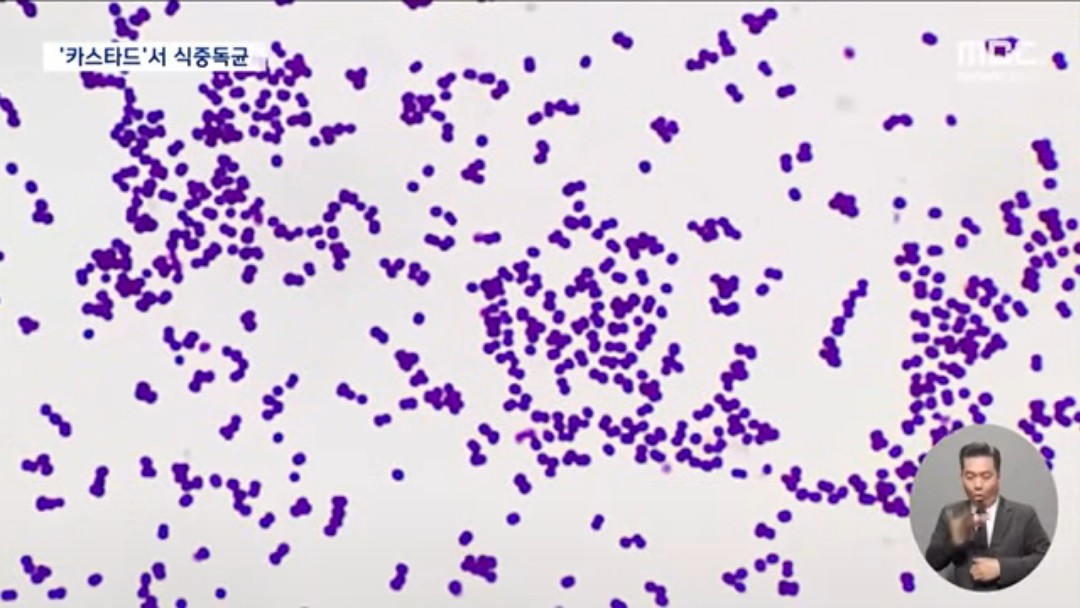

728x90
반응형
오리온 카스타드 판매 중단, 식중독균(황색포도상구균) 검출로 회수 조치
오리온 카스타드
제조일자: 2023년 12월 22일
소비기한: 2024년 6월 21일
23g 과자 12개가 들어있는 276g 제품
구입처에서 반품 가능

오리온의 인기 과자 카스타드에서 식중독균이 발견되어 판매를 중단하고 회수 조치한다고 합니다.
식약처는 어제(3일) 오리온 제4청주 공장이 제조,판매한 해당 제품에서 황색포도상구균이 검출돼 충북 청주시에 판매 중지, 회수 조치를 내렸습니다.


회수대상 제품은 12월 22일 오리온 제4청주공장에서 만들어진 12개입 제품으로 소비기한은 6월 21일로 표기되어 있다고 합니다. 총 4천 776상자가 출고되었다고 하네요.
반응형
제품을 구매하신 분은 먹지마시고, 구입처에 반품하면 된다고 합니다.

황색포도상구균은 포도 송이 모양의 균으로 섭취할 경우 식품에서 독소를 분비해 식중독을 일으키고 구토·설사를 일으킵니다. 음식을 섭취한 뒤 2~3시간 이후에 발병됩니다. 증상이 심한 경우에는 쇼크를 일으키기도 하니 반드시 병원에 방문하여 치료를 받는 것이 좋습니다.
728x90
반응형
'건강·운동' 카테고리의 다른 글
| 오메가3는 왜 영양제로 섭취하는 게 좋을까? 알티지를 먹어야 하는 이유는? (0) | 2024.11.05 |
|---|---|
| 커큐민의 모든 것; 효능, 복용법, 부작용, 염증 잡는 노란 마법 (0) | 2024.11.04 |
| 커피의 건강효과 4가지 (0) | 2023.03.06 |
| 일상생활 속 건강 운동방법 3가지 (0) | 2023.03.06 |
| 영양사가 추천하는 꾸준히 섭취하면 좋은 건강음식 5가지 (0) | 2023.03.05 |



